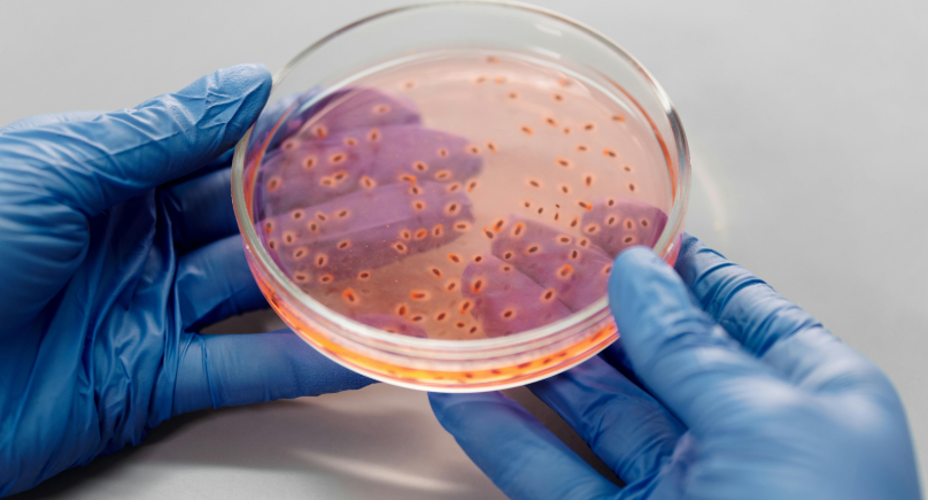

Wednesday 03 12 2025
Amoebae living in a creek in Mumbai are acting as a ‘Trojan horse’ harbouring and protecting multidrug resistant bacteria, according to new research involving University of the West of Scotland (UWS).
The study, led by the University of Strathclyde, and including researchers from UWS, Glasgow Caledonian University and the Indian Institute of Technology, Bombay, discovered that free-living amoebae in Vashi Creek, a tidal estuary in Mumbai, were harbouring bacteria which had far higher levels of antimicrobial resistance (AMR) than those found in the creek’s surrounding sediment.
Nearly half of the bacteria in the amoeba were resistant to four or more antibiotics, rising to six or more in 22 percent of the samples. In marked contrast, the same level of resistance was found in only 0.6% of samples derived from the sediment.
These findings indicate that, while they are normally predators of bacteria, amoebae could serve as “sentinel indicators” of AMR, offering the potential for earlier detection of emerging resistance threats in the environment. The researchers believe this approach aligns with the World Health Organization’s One Health strategy, which seeks a sustainable balance between the health of people, animals, and ecosystems.
The work comes against the backdrop of a major global health challenge, with bacterial AMR directly responsible for an estimated 1.27 million deaths in 2019 and contributing to nearly five million deaths overall.
Leading on UWS’s involvement in the project is Professor Andrew Hursthouse, an environmental geochemist from within the School of Computing, Engineering and Physical Sciences. Discussing the findings, he said: “Our findings highlight the importance of tracking and understanding antimicrobial resistance in the environment and linking it to levels of pollution. By focusing on amoebae in this instance, we uncovered hidden hotspots of antimicrobial resistance activity, which now that it has been identified, gives us an opportunity to strengthen our surveillance systems and ultimately help protect both environmental and public health.
We uncovered hidden hotspots of antimicrobial resistance activity, which now that it has been identified, gives us an opportunity to strengthen our surveillance systems and ultimately help protect both environmental and public health.
Professor Andrew Hursthouse
“What has been particularly powerful about this project is the depth of collaboration across institutions and countries. The research has brought together expertise from engineering, microbiology, geochemistry and public health. It shows what can be achieved when universities and research partners work collectively to tackle global challenges. The research also directly addresses the United Nations Sustainable Development Goals and progresses UWS’s own Strategy 2030 ambitions, particularly in creating and applying new knowledge and growing our global impact.”
Dr Ronnie Mooney, of Strathclyde’s Department of Civil and Environmental Engineering, the lead author of the paper, said: “Environmental reservoirs are increasingly recognised as key contributors to the persistence and spread of AMR, particularly in polluted systems. What we’re seeing is that these environments don’t just contain resistant bacteria; they actively shape and select them.
“Amoebae are abundant in every environment and can act as vectors, transporting clinically relevant bacteria from the environment into high-risk areas such as hospitals or water treatment facilities without being detected. They essentially operate as a microbial Trojan Horse, giving bacteria a protective space in which to survive, adapt, and strengthen their resistance.
“Our research raises important questions about how these hidden reservoirs are being overlooked by current surveillance systems. If amoebae are harbouring highly resistant bacteria, then conventional monitoring approaches may not be capturing the true scale or distribution of antimicrobial resistance in the environment.”
Amoebae are abundant in every environment and can act as vectors, transporting clinically relevant bacteria from the environment into high-risk areas such as hospitals or water treatment facilities without being detected.
Dr Ronnie Mooney
Professor Fiona Henriquez-Mui, UK project lead and Head of the Department of Civil and Environmental Engineering at University of Strathclyde, said: “We know that antimicrobial resistance can develop and spread in the environment, and that interactions between microbes play a major role in this process. Until now, however, these interactions had not been directly linked to the relationship between amoebae and the bacteria they harbour.
“Because many clinically important bacteria are already known to survive digestion by these amoebae, we were particularly concerned that this interaction could drive the development or amplification of antimicrobial resistance in species that already pose risks to human and animal health. Our findings suggest that these concealed reservoirs may accelerate the spread of antimicrobial resistance in precisely those bacteria we can least afford to overlook, and in ways current monitoring systems are not equipped to capture.
“We hope this research will help environmental agencies, industry, and government bodies improve how they monitor antimicrobial resistance in natural and built environments.”
We hope this research will help environmental agencies, industry, and government bodies improve how they monitor antimicrobial resistance in natural and built environments.
Professor Fiona Henriquez-Mui
The research directly addresses the United Nations Sustainable Development Goals, particularly Goal 3, Good Health and Wellbeing; Goal 6, Clean Water and Sanitisation; and Goal 17, Partnership for the Goals.
The UWS team involved in the project also includes Elisa Giammarini, Kiri Rodgers, Ernest Mui and Carla Donet from the School of Health and Life Sciences, and Andrew Hursthouse, from School of Computing, Engineering & Physical Sciences.
The project was funded by the Natural Environment Research Council, part of UK Research and Innovation, and the Department of Biotechnology Government of India.
The research has been published in the journal Environmental Microbiology.